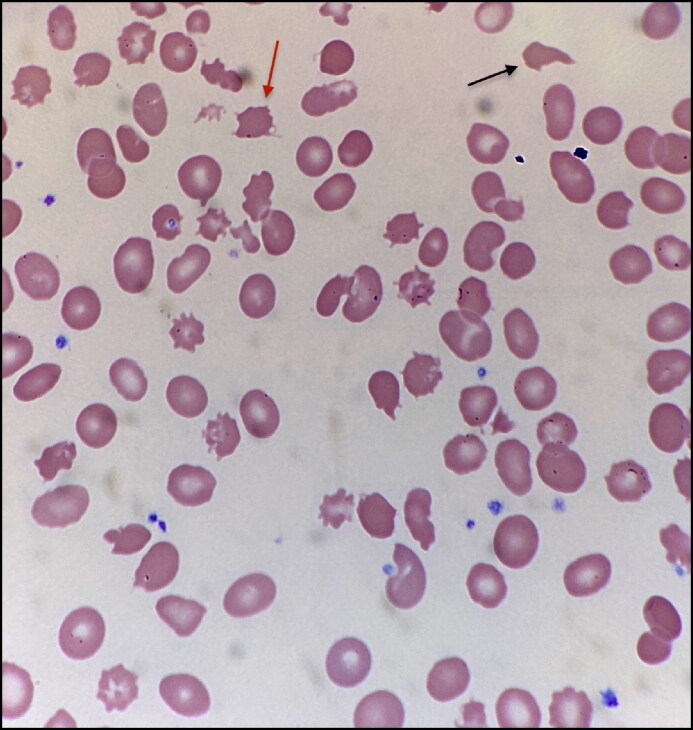
¿Qué es el síndrome de Zieve?

El síndrome de Zieve es una condición clínica poco común que se caracteriza por la presencia de una anemia hemolítica particular y otros síntomas asociados, y se ha observado en individuos con hepatitis alcohólica grave. Esta anemia hemolítica atípica es distinta de la anemia común y está marcada por la presencia de dos tipos de células sanguíneas anormales: espolón y acantocitos.
La hepatitis alcohólica es una inflamación aguda del hígado causada por el consumo excesivo y prolongado de alcohol. En algunos casos de hepatitis alcohólica grave, se ha observado la aparición del síndrome de Zieve, que puede ser una complicación de esta enfermedad hepática.
Los espolones son proyecciones puntiagudas en la membrana celular de los glóbulos rojos (eritrocitos), que se forman debido a la presencia de lípidos en la superficie celular. Los acantocitos, por otro lado, son glóbulos rojos que presentan una serie de espinas o protuberancias irregulares en su membrana. Ambas anormalidades pueden observarse en la sangre periférica mediante un examen de laboratorio llamado frotis sanguíneo.
La anemia hemolítica en el síndrome de Zieve es el resultado de una destrucción acelerada de los glóbulos rojos anormales en la circulación sanguínea. Estos glóbulos rojos con espolón y acantocitos son más frágiles y susceptibles a la destrucción, lo que lleva a una reducción de la cantidad total de glóbulos rojos en la sangre y, por lo tanto, a la anemia.
Además de la anemia hemolítica, el síndrome de Zieve puede estar asociado con otros síntomas, como ictericia (coloración amarillenta de la piel y los ojos debido a la acumulación de bilirrubina), hepatomegalia (aumento del tamaño del hígado) y dolor abdominal en el cuadrante superior derecho debido a la inflamación hepática.
El mecanismo exacto detrás de la formación de espolones y acantocitos en el síndrome de Zieve no se comprende completamente, pero se cree que está relacionado con la alteración en el metabolismo de lípidos y proteínas en los glóbulos rojos debido al daño hepático causado por el consumo de alcohol.
Es importante destacar que el síndrome de Zieve es una condición rara y no se presenta en todos los individuos con hepatitis alcohólica grave. Su diagnóstico se realiza mediante la observación de los glóbulos rojos anormales en un frotis sanguíneo y la identificación de los síntomas asociados. El tratamiento del síndrome de Zieve generalmente se centra en abordar la hepatitis alcohólica subyacente y sus complicaciones, y puede requerir hospitalización y atención médica especializada. La abstinencia completa de alcohol es esencial para mejorar el pronóstico y evitar la progresión de la enfermedad hepática y sus complicaciones asociadas.

Síguenos en X: @el_homomedicus y @enarm_intensivo Síguenos en instagram: homomedicus y en Treads.net como: Homomedicus